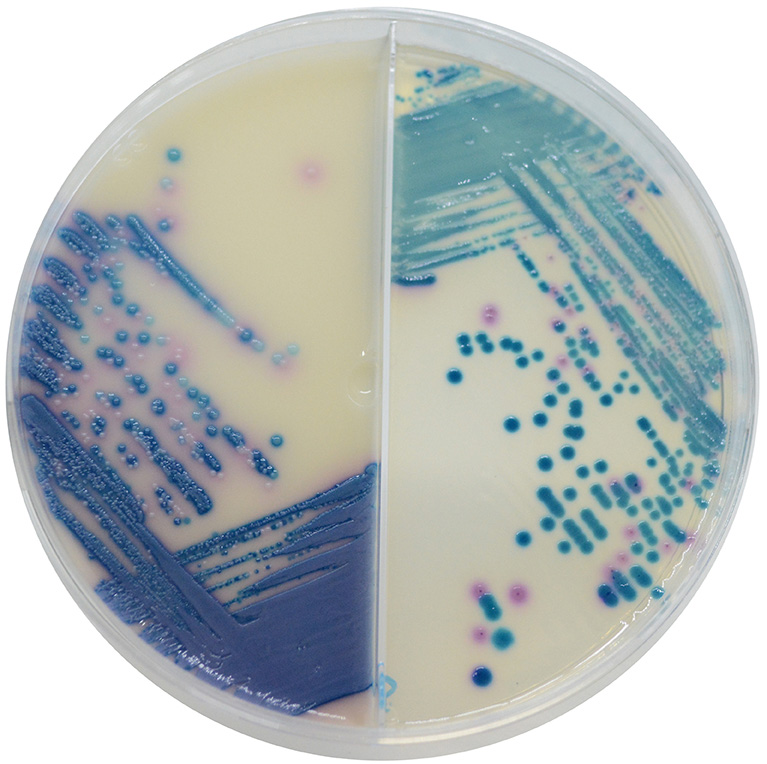

Über das Produkt
Chromogenes Medium zur Isolierung und Differenzierung der wichtigsten Erreger einer Mastitis-Infektion.
Ähnliche Produkte
CHROMagar Mastitis (5L) - ohne CE
Produkte
Mikrobiologie
CHROMagar™ - Fertigplatten
CHROMagar Mastitis Fertigplatten (ohne CE)
CHROMagar Mastitis Fertigplatten (ohne CE)
Chromogenes Medium zur Isolierung und Differenzierung der wichtigsten Erreger einer Mastitis-Infektion.
CHROMagar Mastitis (5L) - ohne CE